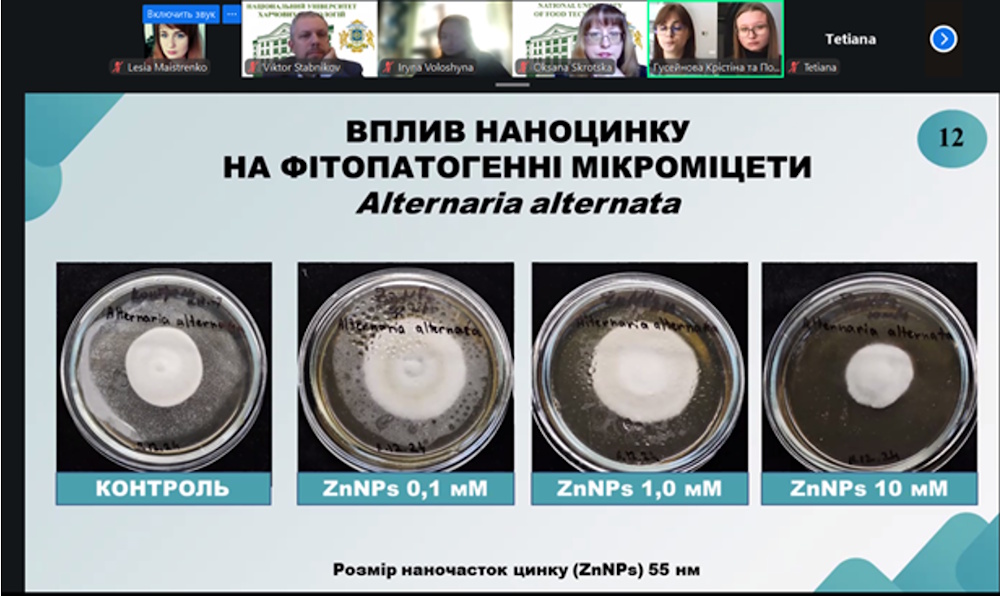

On 22 April 2026, the final scientific and practical conference of the All-Ukrainian student research paper competition in biotechnology took place. Students from Kyiv National University of Technologies and Design attended the competition, including Master's students Kristina Huseynova and Vladyslava Potupa, along with 4th-year student Inesa Korobka. All three represent «Biotechnologist» student research group at the Department of Biotechnology, Leather and Fur.


Kristina Huseynova and Vladyslava Potupa conducted their research under the supervision of Iryna Voloshyna, PhD in Engineering and Associate Professor. Inesa Korobka’s project was supervised by Ihor Hretskyi, PhD in Biology and Associate Professor.
Based on the conference results and the Competition Committee's decision (Minutes of the Competition Committee), Huseynova and Potupa were awarded first place in the «Pharmaceutical and Molecular Biotechnology» section. Their winning study was titled «Biogenic synthesis of nano-zinc using Lactobacillus acidophilus and their effect on microbial cells».

Inesa Korobka secured third place in the «Industrial and Environmental Biotechnology» section for her research on «The Role of Diffusion-Limited Aggregation in the Structural Formation of Yeast Populations».

These impressive achievements are the result of extensive and rigorous laboratory work – from the first experiments and the optimization of conditions to obtaining stable, reproducible data. Beyond conducting experiments, the students refined their practical skills, mastered advanced data analysis methods, and learned to effectively present their scientific findings as a team.
These victories in the All-Ukrainian competition demonstrate the high level of academic excellence and dedication of our students. We congratulate the winners and their supervisors, wishing them continued success, professional growth, and new scientific breakthroughs!
27.04.2026